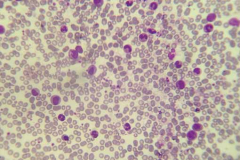
Leucémie lymphoïde chronique

Cancer du col de l'utérus
Le cancer du col de l'utérus est lié à une infection par un virus, le papillomavirus humain. Depuis vingt ans et la généralisation de mesures de dépistage, le cancer du col de l'utérus est...

Le cancer du col de l'utérus est lié à une infection par un virus, le papillomavirus humain. Depuis vingt ans et la généralisation de mesures de dépistage, le cancer du col de l'utérus est...

En France, le cancer de la prostate est le cancer le plus fréquent chez l'homme. Il est le plus souvent diagnostiqué après 70 ans. D'évolution lente, ce cancer est de mieux en mieux soigné et...

Troisième cancer en terme de fréquence globale en France, le cancer du côlon et du rectum fait désormais l'objet d'un dépistage systématiquement proposé aux personnes âgées de...

Le cancer de l'ovaire représente la septième cause de cancer féminin avec environ 4 400 nouveaux cas chaque année en France. Il est fréquemment diagnostiqué à un stade avancé, ce qui rend...

Le cancer du rein est l'une des formes de cancer dont le traitement a le plus évolué au cours des dernières années. Les cancers du rein touchent environ 10 000 Français chaque année, le plus souvent...

En France, le cancer du foie est le plus souvent la complication d'une maladie chronique, la cirrhose hépatique. Les cancers du foie touchent environ 8 000 Français chaque année, le plus souvent des hommes. Ils sont en...

Également appelés cancers des voies aérodigestives supérieures, les cancers du nez, de la bouche et de la gorge font partie des cancers pour lesquels des mesures de prévention existent. En effet, en France, 95 %...

Dans la vaste majorité des cas, les cancers de la vessie peuvent être guéris, même s'ils présentent une forte tendance à récidiver. Les cancers de la vessie représentent environ 10 000...

Le cancer du poumon est la première cause de décès par cancer, en France et dans le monde (avec 20 % des décès liés aux cancers en France). Le tabagisme en est la cause dans 80 à 90 % des cas. Il...

Le cancer du pancréas est fréquemment diagnostiqué à un stade avancé, ce qui rend difficile son traitement. Il reste relativement rare (environ 3 % des cancers), mais l'un des plus craints. Lorsque cela est...

Le cancer du sein est le cancer le plus fréquent chez la femme, avant ou après la ménopause. Sous le terme de cancer du sein sont regroupés plus d'une douzaine de cancer différents qui ont chacun leurs...

Le cancer de la thyroïde, s'il reste relativement rare, est de plus en plus souvent diagnostiqué. Il est plus fréquemment observé chez les femmes autour de l'âge de la ménopause. Dans plus de 90 % des...
La leucémie lymphoïde chronique est un cancer des cellules du sang qui affecte une variété de cellules du système immunitaire, les lymphocytes B. Dans la majorité des cas, la leucémie lymphoïde...

Les lymphomes sont des cancers qui affectent certaines cellules du système immunitaire, les lymphocytes (une variété de globules blancs). Il en existe de plusieurs types, dont la maladie de Hodgkin qui survient souvent chez...

Le mélanome est l'une des formes les plus graves de cancer de la peau (cutanés). Même s'il ne représente que 10 % des cancers cutanés, le mélanome est à l'origine de la grande...

Le myélome multiple est un cancer du sang qui affecte un type de cellules du système immunitaire, les plasmocytes (des globules blancs qui se trouvent en grand nombre dans la moelle osseuse). De cause inconnue, le myélome...

Les tumeurs du cerveau regroupent plusieurs formes de cancers selon les cellules atteintes, la localisation de la tumeur et la vitesse de son évolution. Elles représentent environ 4 500 nouveaux cas de cancers chaque année en...